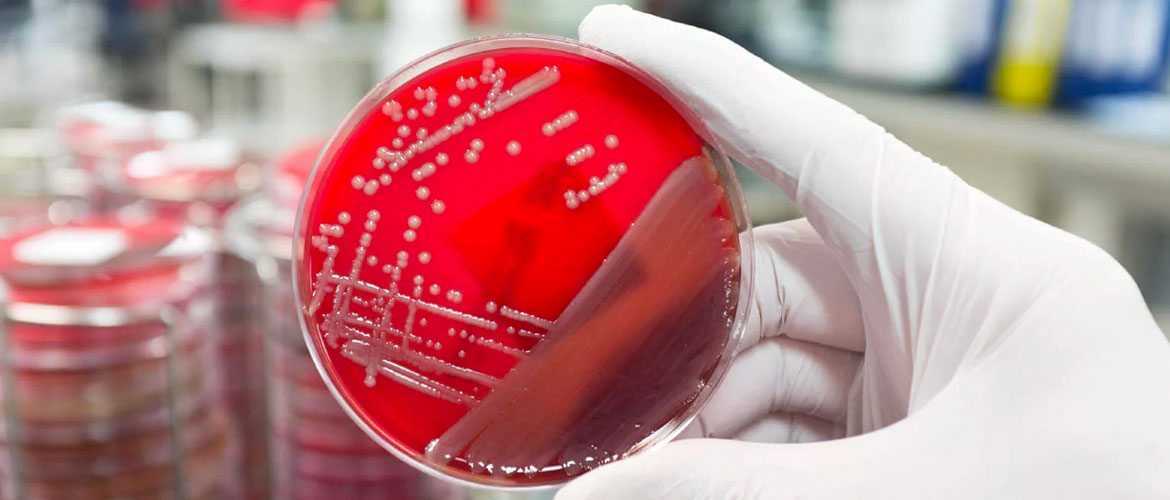
hlamidioz-u-zhenshchin-simptomy-i-lechenie-2.jpg

Хламидия трахоматис (chlamydia trachomatis) является возбудителем хламидиоза опасного заболевания у женщин. Симптомы болезни после заражения у каждого человека могут быть отличны, так как клинические проявления зависят от состояния иммунной системы. Осведомлённость о том, откуда берётся бактерия, как передаётся, поможет избежать заражения и лечить заболевание не придётся.
Что такое хламидиоз пути заражения
Хламидиоз патологический процесс, инициатором которого являются микроорганизмы под названием хламидии.
Инфицирование происходит по-разному. Возможные пути передачи:
- Половой (является ведущим). Местом локализации первичного воспаления становится слизистая влагалища. Позднее не исключено продвижение патогена вверх по половым путям. Это приводит к поражению шейки матки, фаллопиевых труб, сопровождающемуся образованием тяжей и вызывающее их непроходимость. При внедрении микроорганизмов в просвет мочеиспускательного канала и попадании в полость мочевого пузыря развивается цистит. К заражению приводит любой незащищенный половой акт с носителем. Это касается как традиционного сексуального контакта, так и анального, и орального варианта.
- Вертикальный (от матери к ребенку при естественных родах). Хламидии сильные микроорганизмы, поэтому инфекция передается малышу при прохождении по родовым путям. У младенца могут поражаться глаза (формируется конъюнктивит) либо легкие (пневмония).
- Контактно-бытовой. Медиками не доказано, что болезнь передается подобным способом, но предположения имеются. Хламидии сильные микроорганизмы, сохраняющие активность вне тела носителя до двух суток. Потенциальными источниками заражения могут выступать полотенце, нижнее белье, стульчак унитаза, которыми пользовался носитель инфекции.
- Воздушно-капельный (редкое исключение). Характерен для передачи Chlamidia pneumoniae от человека с диагностированным хламидийным воспалением легких.
Хламидия трахоматис у женщин является одной из наиболее распространенных инфекций, передающихся половым путем. Врачи отмечают, что основной путь передачи инфекции — незащищенные половые контакты с инфицированным партнером. Однако существует и ряд других факторов, способствующих распространению хламидийной инфекции. Например, женщины, имеющие несколько половых партнеров, находятся в группе риска. Также врачи подчеркивают, что отсутствие регулярных медицинских осмотров и тестирования на ИППП может привести к незамеченному течению заболевания, что в свою очередь увеличивает вероятность передачи инфекции. Важно отметить, что хламидия может передаваться не только через половой контакт, но и от матери к ребенку во время родов, что подчеркивает необходимость ранней диагностики и лечения. Врачи рекомендуют женщинам быть внимательными к своему здоровью и регулярно проходить обследования, чтобы предотвратить развитие осложнений, связанных с хламидийной инфекцией.
Характерные особенности
Хламидия Трахоматис имеет следующие характерные особенности:
- Паразитирует внутри клетки. Chlamydia trachomatis синтезировать АТФ не может, поэтому стремительно поглощает энергетические ресурсы клетки, приводя к полному ее разрушению. Это свойство объединяет их с вирусам.
- Chlamydia trachomatis имеет клеточную оболочку. В этом их сходство с бактериями. Из за этого свойства возможно применение антибиотиков.
- В зависимости от антигенных серотипов вызывает поражение глаз (трахому); коньюктевит; урогенитальную инфекцию и может вызвать венерическую лимфогранулему.
- Обладает уникальным жизненным циклом.
Особенности бактерии, клинические проявления
Из-за строения и способности хламидии скрываться от иммунной системы, проникая внутрь клетки, её часто путают с вирусом. Изначально бактерия распространялась только среди животных и птиц. В ходе эволюции и под действием мутаций она стала проникать в клетки человека. Сейчас, по данным, МОЗ хламидиями заражено 60 % людей. Микроорганизм способен жить только в теле, поскольку вне его из-за слабой устойчивости к внешним условиям он быстро погибает.
Попадая в благоприятную среду, бактерия начинает размножаться путём деления. Она травмирует слизистые оболочки половых органов. Отмечают выброс токсинов в кровоток, которые и провоцируют клинические проявления. Нередки ситуации, когда инфекция протекала скрытно. Её обнаруживали в ходе обследований. У хламидии нет митохондрии она не способна производить энергию. Это характеризует микроорганизм как внутриклеточного паразита.
К распространенной инфекции, с которой сталкиваются венерологи, относят хламидиоз уретрального типа, развивающийся на фоне проникновения бактерий. Большему риску заражения подвержены женщины. И хотя течение инфекции зачастую у них бессимптомно, болезнь приводит к серьёзным дисфункциям работы половых органов. Почти у 70 % женщин с диагностированным хламидиозом отмечают проблемы с зачатием ребёнка.
Если бактерия попадает в организм с сильным иммунитетом, она может уйти в сон. Больной будет оставаться носителем, даже не подозревая об этом. Активизируется хламидия только после изменения условий на благоприятные для размножения. Реже сильная иммунная система даже способна уничтожить инфекцию, пока бактерия не успела замаскироваться.
Хламидия трахоматис — это инфекция, о которой часто говорят в контексте полового здоровья. Многие женщины задаются вопросом, откуда берется эта бактерия и как она попадает в организм. Основной путь передачи — это незащищенные половые контакты с инфицированным партнером. Однако, существует и риск передачи инфекции от матери к ребенку во время родов.
Некоторые женщины отмечают, что отсутствие симптомов делает диагностику сложной, и многие даже не подозревают о наличии инфекции. Это приводит к тому, что хламидия может долгое время оставаться незамеченной, что увеличивает риск осложнений, таких как воспалительные заболевания органов малого таза.
Важно помнить, что регулярные медицинские обследования и использование барьерных методов контрацепции могут значительно снизить риск заражения. Обсуждение темы с партнерами и открытость в вопросах здоровья — ключевые моменты для профилактики.
Жизненный цикл
Chlamydia trachomatis имеет две фазы развития.
- Первая фаза присоединение Chlamydia trachomatis к клетке человека. У женщин они присоединяются к маточным трубам, эндометрию. Существуя вне клетки, хламидии образуют элементарные тельца. В этом состоянии хламидии заразны.
- Вторая фаза проникновение непосредственно в клетку. В клетке она создает вокруг себя фагосому, в которой происходит ее дальнейший рост. В одной клетке могут помещаться несколько элементарных телец Chlamydia trachomatis. Затем из элементарного тельца она перерождается в ретикулярное. Через 18-20 часов ретикулярные тельца снова превращаются в элементарные. Этот процесс длится 48 -72 часа и в течение этого времени развиваются от 200 до 1000 новых телец.
Антибиотики любого поколения эффективны только по отношению к ретикулярным тельцам. На элементарные тельца они не действуют. Поэтому инфекция Chlamydia trachomatis принимает хроническую форму и плохо поддается лечению.
Как передается Chlamydia trachomatis и какой инкубационный период? Пути заражения
Передача Chlamydia trachomatis происходит несколькими путями:
- половой контакт;
- передача от больной матери к ребенку во время родов;
- контактно бытовой (находится под вопросом).
Контактно бытовой способ теоретически возможен, т. к. Chlamydia trachomatis находили в общественных туалетах, на полотенцах. (Сохраняется до двух суток). Но документально не подтвержден.
Инкубационный период длится от двух недель до одного месяца.
В настоящее время прослеживается тенденция уменьшения времени инкубационного периода до 10 дней.
Половой
Более распространённый способ. При незащищённом половом акте (без применения барьерных контрацептивов) бактерия переходит от больного человека к здоровому. Потенциально опасны все виды секса и классический, и нетрадиционный. Хотя при оральном половом акте заражение менее вероятно, поскольку прижиться микроорганизм может только в глотке. По данным МОЗ, женщины, имеющие несколько половых партнёров, попадают в группу повышенного риска.
Вертикальный
Ещё один путь, который имеет место только, если больная хламидиозом женщина беременеет, а заболевание в период вынашивания ребёнка развивается с той же интенсивностью. Патогенный организм поражает неокрепшие клетки новорожденного. Иногда инфицирование младенца заканчивается летальным исходом.
Бытовой
При нарушении правил личной гигиены возможно заражение хламидией трахоматис как у женщин, так и мужчин. Чаще отмечают инфицирование через использование одного нижнего белья, полотенец, ложки, вилки. Дружеские поцелуи не исключение. Вопреки расхожему мнению, через ободок унитаза заразиться венерическим заболеванием нельзя, так как бактерия не способно долго прожить вне клетки.
Симптомы хламидиоза у женщин
Какими признаками может проявляться заболевание? Точно выявить хламидиоз довольно сложно, поскольку для него типично бессимптомное течение. Проявления встречаются лишь у 33% пациенток.
Инкубационный период болезни довольно продолжительный. Первые признаки заболевания и неприятные симптомы появляются через 14 30 суток после заражения.
Чаще других разновидностей диагностируется урогенитальный хламидиоз, хотя существуют и другие формы.
Присутствие патогена можно определить только лабораторным путем. Потенциальными симптомами патологии выступают:
- Повышение температуры тела один из основных симптомов острой формы. Показатели в этот период достигают 37 37,5 С.
- Боли. Область локализации нижняя часть живота, поясница. По силе бывают как достаточно ощутимыми, так и слабыми. Могут полностью отсутствовать.
- Нарушение мочеиспускания. При вовлечении в патологический процесс мочеиспускательного канала, у женщин появляются симптомы цистита. Это жжение, рези при попытке освобождения мочевого пузыря, увеличение количества позывов помочиться.
- Нехарактерные вагинальные выделения.
- Жжение слизистых. Признаками хламидий может выступать чувство жжения, поскольку именно слизистые поверхности являются основным местом жительства возбудителя.
- Эрозия шейки матки. Хроническая форма может становиться причиной образования эрозированных участков на шейке матки.
Инфекция становится частой причиной развития гинекологических патологий. На ее наличие могут указывать:
- Кольпит (воспаление слизистой вагины). Кольпит этой разновидности часто диагностируется у беременных женщин и дам в период менопаузы, поскольку для этих периодов типичен дефицит эстрогенов. У больной появляются такие неприятные симптомы, как жжение, зуд, нехарактерные бели, нарушение процесса мочеиспускания, болезненность внизу живота, незначительный рост общей температуры.
- Цервицит (воспаление тканей шейки матки). И острый, и хронический урогенитальный хламидиоз способен провоцировать формирование воспалительного процесса. В ходе осмотра гинеколог отмечает увеличение шейки матки в результате отечности. Лечение необходимо обязательно провести, поскольку в дальнейшем не исключено развитие эрозии.
- Эндометрит (поражение слизистого слоя матки), сальпингит (воспаление фаллопиевых труб), сальпингоофорит (сочетанное воспаление яичников и маточных труб). Формирование патологических состояний обусловлено восхождением инфекции вверх по половым путям.
Симптомы Хламидии Трахоматис у женщин
Довольно часто хламидиоз протекает бессимптомно, что приводит к поздней диагностики и лечению. Более поздние симптомы болезни выражаются в следующем:
- выделение из влагалища;
- небольшие кровотечения из влагалища;
- боль при мочеиспускании;
- боль внизу живота.
Наиболее частые заболевания, вызываемое хламидией трахоматис:
- хламидийный цервицит (поражение шейки матки);
- сальпингит (поражение мочеточников);
- эндометрит (воспаление внутреннего слоя матки);
- уретрит, цистит (воспаление мочевого пузыря);
- бартолинит (воспаление бартолиновой железы).
Хламидия Трахоматис легко передвигается по крови и лимфе, поэтому могут поражаться суставы, глотка, конъюнктива глаз и другие органы человека.
При проведении длительной терапии антибиотиками, нарушается естественная флора кишечника. Это способствует присоединению грибковой инфекции с развитием кандидоза.
Выделения при заболевании
При развитии урогенитальной формы характер вагинальной слизи изменяется не сразу. Инкубационный период заболевания равен 2-4 неделям. По истечении этого времени можно заметить его основные симптомы.
У женщин появляются бесцветные прозрачные бели. В случае присоединения вторичной инфекции, происходит изменение цвета отделяемого. Оттенок может варьироваться от белого до темновато-коричневого. Не исключено присутствие гнойных примесей. На осложненное течение заболевания указывает появление неприятного запаха. Это симптом может говорить о развитии гонореи.
Количественные характеристики выделений не изменяются, т.е. объем белей остается на прежнем уровне. При этом большая часть отделимого собирается в просвете уретры, поэтому во время утреннего мочеиспускания женщина может отмечать появление слизи в моче.Консистенция выделений остается водянистой. Если бели становятся липкими, то это признак присоединения вторичной инфекции.
Первые признаки заболевания в виде изменения влагалищных белей формируются спустя 7 14 суток после инфицирования.
Но в большей части случаев признаки полностью отсутствуют.
Диагностика хламидий какие анализы нужны
Поскольку симптомы патологии нехарактерны, диагностируется состояние случайно в период прохождения обследования у гинеколога по иному поводу.
Если у женщины присутствуют потенциальные признаки заболевания, то больной назначаются различные тесты. Ведущими являются:
- исследование вагинального мазка на присутствие бактерий;
- анализ крови на антитела определяются характерные антитела, указывающие на развитие болезни;
- ПЦР-тест позволит точно выявить хламидиоз, поскольку позволяет определить генетический материал патогена;
- бактериальный посев помогает диагностировать состояние с вероятностью в 70%, определить разновидность возбудителя, подобрать антибактериальные препараты, чтобы разработать схему лечения;
- иммунофлуоресценция определяет возбудителя с 50%-ной вероятностью.
Больной проводится УЗИ-исследование органов малого таза. Процедура помогает выявить скрытые признаки состояния в виде структурных изменений матки, фаллопиевых труб и яичников.
После перенесенного хламидиоза у человека вырабатывается временный, так называемый нестерильный иммунитет, поэтому повторное заражение исключать нельзя.
Особенности женского хламидиоза
Особенно опасен хламидиоз у женщин. Симптомы заболевания чаще всего отсутствуют, поэтому за медицинской помощью пациентки обращаются поздно. Как правило, при хронизации болезни, поскольку признаки острого процесса остаются незамеченными.
При отсутствии медикаментозной поддержки организма не исключено развитие серьезных осложнений. К тому же, женщина является источником заражения.
Хламидиоз при беременности
Наличие инфекции у беременных женщин может негативно отражаться на течении гестации. Самыми тяжелыми исходами выступают самопроизвольный аборт либо внутриутробная гибель плода. Причиной становится развитие плацентарной недостаточности, которую вызывает хронический хламидиоз.
Лечение хламидиоза у женщин во время вынашивания ребенка необходимо проводить поэтапно, комплексно, принимая во внимание имеющиеся противопоказания. Схемы терапии инфекции, выявленной у беременных, стандартные. В процессе используются препараты Ровамицин и Эритромицин. В этот период запрещено применение средств из группы фторхинолонов и Доксициклин.
Хламидия Трахоматис у женщин при беременности: влияние на плод
| Беременность | Влияние на плод | Исход |
| До 15 дней | Патология зародыша(бластопатия). | Разрушение плодного яйца. |
| До 12 недель | Заболевание и повреждение зародыша (эмбриопатия). | Пороки развития маточных труб. |
| После 12 недель | Преждевременные роды; расстройства плода (фетопатии), воспаление оболочек плода (хориоамнионит). | Внутриутробная патология плода; недоношенность;. эндометрит у матери. |
Как видно, осложнения при заболевании Chlamydia trachomatis очень серьезные при беременности.
Рекомендуется при малейшем подозрении на хламидиоз, пройти своевременное лечение.
При назначении врачом медикаментозных препаратов необходимо точно следовать предложенным дозам и не прекращать самостоятельно прием лекарств. Выжившие хламидии приобретают устойчивость к данному препарату, и время полного излечения продолжается и усложняется.
Самолечение беременным женщинам категорически запрещено!
Норма Хламидии Трахоматис у женщин
Chlamydia trachomatis в организме человека не должна быть. Антитела класса IgA и IgG не должны быть обнаружены в крови.
Обследование и лечение Хламидии Трахоматис должно осуществляться всеми половыми партнерами. Вакцин от хламидиоза нет, иммунитет на заболевание не вырабатывается.
Лечение
Терапия венерического заболевания комплексное мероприятие. Базисный приём применение антибактериальных средств. Поскольку у внутриклеточного паразита высокая чувствительность к антибиотикам, вылечить больного возможно. Но это непросто. Основная причина состоит в важности расчёта правильного типа и дозировки. Последняя будет зависеть от состояния иммунной системы и наличия прочих инфекций половых органов.
Определение всех факторов требует комплексного анализа. Самостоятельно это невозможно. Терапия лишь антибиотиками при наличии бактерий в организме недопустима. Помимо того, что это может спровоцировать ухудшение общего состояния носителя, но и привести к развитию хронической формы венерической болезни. Лечение проводят средствами таких групп:
- макролиды;
- пенициллины;
- тетрациклины.
Если стандартные препараты не оказывают ожидаемого действия, прибегают к резервным в виде фторхинолонов. У бактерии наблюдают сопротивляемость к одному из средств. Врач назначает препарат из другой группы. Азитромицин демонстрирует высокую продуктивность. Чтобы уничтожить всех внутриклеточных паразитов, находящихся у женщины, назначают однократный приём препарата (2 таблетки сразу). Исключение вынашивающий ребёнка. Иногда применяют более щадящую схему терапии, разбивая курс на 5 дней:
- первые сутки показано 500 мг;
- далее по 250 мг.
Доксициклин также противопоказан при беременности. Остальным больным врач может назначить недельный курс, а течение которого надо пить дважды в сутки по 100 мг. Если же в качестве основного средства выбран Ампициллин, длительность терапии 10 дней. Ежедневно больному назначают по 1 г, который делят на четыре приёма с равными промежутками.
При вынашивании ребёнка подбор средств для лекарственной терапии более тщателен. Из-за высокой токсичности многие препараты противопоказаны беременным. Если хламидиоз выявили у женщины на ранних сроках, лечение лучше отложить до второго триместра, когда сформируется плацента. Чаще во время терапии применяют Эритромицин.
Лечение антибиотиками, уничтожающими и полезные бактерии, должно проходить одновременно с курсом терапии от дисбактериоза. Назначают пробиотики. Антибиотики элемент терапии. Но они не единственные средства, которые нужны для выздоровления. Врач назначает витамины и средства, стимулирующие иммунную систему. Иногда хламидиоз осложняется вторичной грибковой инфекцией половых органов кандидозом. В качестве терапевтического лекарства показано противогрибковое.
При заражённости обоих половых партнёров лечение должно быть одновременным, иначе все приложенные силы по уничтожению внутриклеточных паразитов будут напрасны. Повторное заражение произойдёт при следующем половом акте. Заболевание не формирует специфический иммунитет относительно бактерий после выздоровления. Переболевшая хламидиозом женщина легко заразится им повторно, если будет иметь контакт с носителем. Есть несколько болезней у мужчин, которые указывают на наличие хламидий с вероятностью до 70 %: уретрит и простатит.
Во время терапевтического курса от половых контактов надо воздержаться. Соблюдать рекомендацию надо до подтверждения врачом факта, что ни один из партнёров не носитель бактерий. Для проверки эффективности лечения после его завершения проводят контрольные исследования на наличие возбудителей. Анализы сдают спустя две недели, месяц и два месяца.
Антисептические препараты назначают наравне с антибиотиками общего спектра действия. При поражении мочеполовых органов лекарства воздействуют на возбудителя болезни. Препротивная форма может отличаться вагинальные свечи, мази. Ещё используют ванночки, тампоны и микроклизмы с антисептиком в составе. Есть ряд препаратов, содержащих бактериофаги. В отдельных случаях в качестве вспомогательной меры терапии могут назначать физиопроцедуры облучение ультразвуком и лазером, магнитотерапия, электрофорез.
Лечение женского хламидиоза
Клинические рекомендации разрабатывается индивидуально в каждом конкретном случае. Лечение хламидиоза у женщин проводится комплексно и предполагает использование следующих групп лекарственных средств:
- антибактериальные препараты;
- иммуностимуляторы;
- поливитамины.
Неотъемлемой частью протокола становятся внесение корректив в рацион больной, физиопроцедуры, местные средства (суппозитории).
Наиболее часто используемые антибактериальные препараты:
- Доксициклин (тетрациклиновый ряд). Относится к антибиотикам широкого спектра действия. На фоне приема может возникать нарушение пищеварения, поэтому его необходимо сочетать С ферментными средствами и пробиотиками. Продолжительность курса 10-14 дней.
- Азитромицин (из группы макролидов). Его отличает минимум побочных эффектов. Применяется однократно. Дозировка 1 грамм. При плохой переносимости активного вещества ее можно поделить на несколько приемов.
- Джозамицин (активное действующее веществ вильпрафен). Назначается в случае привыкания патогена к доксициклину и азитромицину.
Хороший терапевтический эффект обеспечивают следующие лекарственные средства:
- Эритромицин, Спирамицин (из группы макролидов);
- Офлоксацин, Левофлоксацин, Ципрофлоксацин (группа фторхинолонов) могут комбинироваться с другими разновидностями антибиотиков по показаниям;
- Амоксициллин (пенициллиновый ряд).
Если женщина находится в условиях стационара, то допускается комбинирование антибактериальных и противомикробных средств.
Физиопроцедуры
При диагностировании патологии часто используются физиопроцедуры. Могут назначаться:
- облечение ультразвуком;
- электрофорез;
- магнитотерапия.
Какое влияние оказывают физиопроцедуры на течение заболевания?
- На фоне применения ультразвука происходит повышение иммунной защиты, устраняется симптоматика воспалительного процесса, ускоряется течение процессов самостоятельного восстановления поврежденных тканей.
- Магнитотерапия способствует снятию имеющейся патологической симптоматики, отечности внутренних органов, устранению болевого синдрома.
- Электрофорез обеспечивает обезболивающий, противовоспалительный, сосудорасширяющий эффект. Улучшает течение обменных реакций.
Вне зависимости от выбранного метода отмечается улучшение общего самочувствия: уходят боли, отечность, повышается иммунитет (общий и местный).
Иммуномодуляторы
Терапевтический протокол предусматривает обязательный прием иммуномодуляторов препаратов, улучшающих иммунную защиту организма.
Лечебный курс включает прием следующих средств (на выбор доктора):
- Полиоксидоний. Способствует повышению иммунной защиты, более активной выработке антител. Препарат стимулирует активность фагоцитов крови, снижает токсическое воздействие на клетки печени других лекарственных средств. Прием проводится по следующей схеме: 1 раз в двое суток, внутримышечно в дозировке 6 мг. Полиоксидоний противопоказан в период вынашивания ребенка и грудного вскармливания;
- Тималин. Препарат усиливает клеточный иммунитет, усиливает фагоцитоз. Курс равен 10 дням. Дозировка внутримышечно 5 20 мг, ежедневно. Противопоказанием является индивидуальная непереносимость компонентов. На фоне терапии не исключено развитие признаков аллергии.
Поливитамины при хламидиозе
Схему лечения болезни дополняют различные поливитаминные комплексы. Они восполняют нехватку необходимых витаминов и микроэлементов, улучшая работу иммунной системы.
Чаще всего применяются следующие препараты:
- Аевит. Представляет собой сочетание витамина А и Е. Способствует усилению иммунной защиты, укрепляет стенки сосудов. У женщин схема приема 1 таблетка дважды в сутки. Противопоказанием к применению являются непереносимость компонентного состава, нарушение кровообращения, диагностированная тромбоэмболия. На фоне лечения не исключены проблему с пищеварением.
- Витрум. Устраняет дефицит необходимых организму витаминов, усиливает его сопротивляемость. Курс приема определяется индивидуально. Дозировка 2 таблетки в день. Противопоказанием к применению становятся повышенная чувствительность к компонентам Витрума, туберкулез, саркома, тромбофлебит, сердечная недостаточность. Не исключено развитие побочных реакций в виде симптомов аллергии: кожные высыпания по типу крапивницы, зуд.
Действенные схемы лечения
Эффективные схемы лечения хламидиоза многочисленны. В основе их действия лежит прием лекарственных средств, уничтожающих патоген. Перед выбором препаратов медик дает оценку текущего состояния больной, определяет наличие сопутствующих патологий и только на основании данной информации подбирает медикаменты. Курс должны пройти оба половых партнера.
Схема терапии разрабатывается в зависимости от формы хламидиоза:
- Острый. В процессе используется антибиотик (чаще всего Доксициклин назначается на 3 недели, дважды в день по 100 мг), иммуномодулятор и поливитаминный комплекс. Через неделю от начала приема антибиотика назначаются ферментные препараты. При развитии молочницы применяются противогрибковые средства Нистатин (500 000 ед), Флуконазол. Одновременно к приему назначаются гепатопротекторы, пробиотики, рекомендуются физиопроцедуры;
- Вялотекущий. В течение первых 14 суток назначается прием энзимов и иммуностимуляторов. На следующем этапе схема дополняется поливитаминами, антибиотиками (используется вариант терапии острой формы), противогрибковыми средствами.
Терапия хронической инфекции проводится по следующей схеме:
- В первые 14 суток больная принимает Амиксин 1 таблетка через день в течение календарного месяца энзимы.
- Через 10 дней от начала терапии назначается прием антибиотиков (схема аналогична острой форме) и поливитаминных комплексов.
- Лечение дополняется приемом гепатопротекторов, получением физиопроцедур. Хорошие результаты дает использование суппозиториев Лонгидаза (1 свеча один раз в 10 дней).
При разработке терапевтической схемы учитываются другие заболевания половой сферы. Это помогает врачу подобрать максимально действенный антибиотик, который будет эффективен не только против хламидий.
На излечение указывает отрицательный результат проведенного ПЦР-теста. Выполнить исследование нужно спустя 30 45 дней после завершения медикаментозного курса.
Что будет если не лечить?
Воспалительные процессы, сопровождающие хламидийные инфекции, способны вызывать различные осложнения. Самые серьезные последствия запущенной болезни сложность с зачатием, полное бесплодие, высокий риск появления злокачественных образований.
Типичные осложнения состояния:
- Сальпингоофорит/сальпингит. Воспаления придатков матки или только фаллопиевых труб опасные заболевания, поскольку препятствуют наступлению беременности. Образование рубцовой ткани в просвете маточных труб ведет к их непроходимости, что становится причиной бесплодия;
- Эндоцервицит (поражение канала шейки матки). При подобном диагнозе увеличивается вероятность развития раковых образований;
- Эндометрит (воспаление в слизистой матки). Состояние затрудняет наступление беременности из-за сложностей с закреплением оплодотворенной яйцеклетки. Также увеличивается риск самопроизвольного аборта.
Тяжелым осложнением хронической формы является развитие синдрома Рейтера.
Осложнения
Если бактерия находится в организме, и она не лечилась, осложнений не миновать. Врач при обследовании определяет заболевания половых органов. Если у мужчин присутствие хламидии находит выражение в эпидимите, орхите и простатите, то у женщин характерны цистит, вагинит и прочие болезни шейки матки. Часто они даже не обращаются в больницу, поскольку не думают, что это состояния, сопровождающие хламидиоз. Они продолжают поверхностное лечение.
https://youtube.com/watch?v=ivhNVPHQQEA
Развитие патогенных организмов приводит и к бесплодию. Но у женщин это необязательно находит выражение лишь неспособности зачать ребёнка. Чаще трудности касаются вынашивания плода, так как наблюдают неправильную работу половых органов, включая матки. Её сокращение тяжело контролировать. Больных с подозрением на хламидиоз необходимо наблюдать в стационаре.
Если заболевание обнаружено на ранних этапах, пока не произошло необратимых процессов, бесплодие излечимо. При отсутствии терапии хламидиоза страдают суставы. Их болезнь развивается из-за аутоиммунной реакции на присутствие внутриклеточного паразита. Если, помимо урогенитальных симптомов и болей в суставах, отмечают конъюнктивит, это свидетельствует о развитие синдрома Рейтера. Последний плохо поддаётся лечению.
Профилактика хламидиоза
Профилактика состояния несложная и заключается в отказе от незащищенного полового контакта. Во время секса с малознакомым половым партнером необходимо использовать кондом.
Своевременное диагностирование и получение адекватной терапии значительно улучшает прогноз заболевания. Как правило, для полного излечения инфекции при отсутствии вторичных осложнений требуется не больше двух недель. При хронизации процесса прогноз ухудшается, именно поэтому женщиной должна быть правильно оценены появившиеся симптомы и лечение начато сразу. В противном случае повышается риск возникновения спаек и формирование трубно-перитонеального бесплодия.
Вопрос-ответ
Как происходит заражение Хламидией трахоматис?
Заражение Хламидией трахоматис происходит преимущественно через незащищенные половые контакты с инфицированным партнером. Бактерия может передаваться как при вагинальном, так и при анальном или оральном сексе. Также возможно заражение от матери к ребенку во время родов.
Какие симптомы могут указывать на инфекцию Хламидией трахоматис?
У женщин инфекция может протекать бессимптомно, но возможны такие симптомы, как необычные выделения из влагалища, боль при мочеиспускании, боли внизу живота и дискомфорт во время полового акта. Важно проходить регулярные обследования, так как отсутствие симптомов не исключает наличие инфекции.
Как можно предотвратить заражение Хламидией трахоматис?
Для предотвращения заражения рекомендуется использовать барьерные методы контрацепции, такие как презервативы, а также регулярно проходить медицинские обследования на наличие инфекций, передающихся половым путем. Важно также ограничивать количество половых партнеров и вести открытый диалог о здоровье с ними.
Советы
СОВЕТ №1
Регулярно проходите медицинские обследования. Профилактика и раннее выявление инфекций, передающихся половым путем, включая хламидии, могут значительно снизить риск осложнений и распространения инфекции.
СОВЕТ №2
Используйте барьерные методы контрацепции, такие как презервативы, при каждом половом акте. Это поможет защитить вас и вашего партнера от передачи хламидий и других инфекций.
СОВЕТ №3
Обсуждайте с партнерами вопросы здоровья и тестирования на инфекции. Открытое общение поможет вам обоим быть в курсе состояния здоровья и принимать меры для его защиты.
СОВЕТ №4
Изучайте информацию о хламидиях и других инфекциях. Знание о путях передачи, симптомах и методах лечения поможет вам лучше защищать свое здоровье и здоровье партнеров.